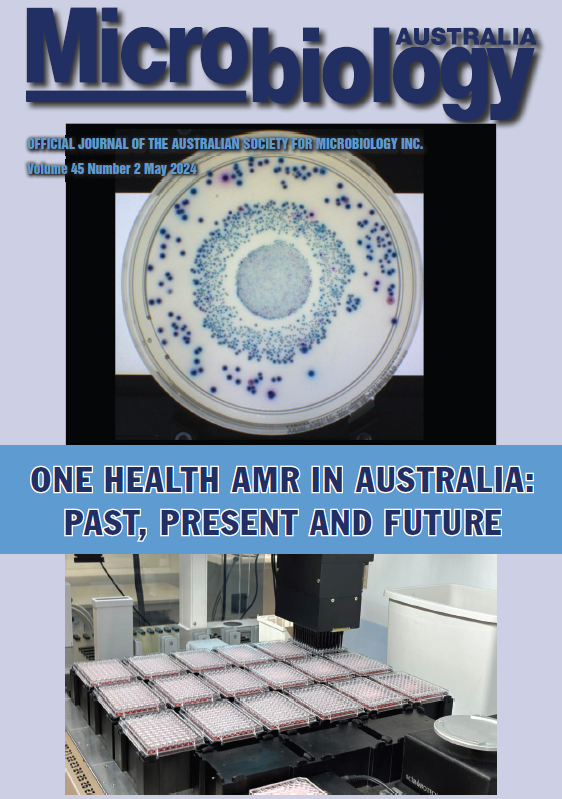

ASM SA/NT Branch
@asm_sant_branch
The official Twitter account of the South Australia / Northern Territory Branch of the Australian Society for Microbiology (@AUSSOCMIC).
ID: 1187541403141754881
http://www.theasm.org.au 25-10-2019 01:28:39
170 Tweet
159 Takipçi
103 Takip Edilen




Interested in #phages? Check out the World Health Organization (WHO) webinar about the environmental use of phages and register below! 🗓️May 16th 🕖7 pm AWST 📍 Online More info: who.zoom.us/webinar/regist…









Industry Engagement Award winner Dr Erin Brazel telling us about her work developing a serotype-independent vaccine for pneumococcus #ASM2024


An amazing talk from ASM SA/NT Branch student awardee Brynley Davies from EijkelkampLab Flinders University on the role of #lipids during #bacterial infection. #ASM2024





Congratulations to the awardees of our ASM SA/NT Branch Conference Travel Awards! We are delighted to be supporting Rachel Chin and Mohammad Mahzounieh to participate in the BacPath 17 conference in November! ASM



Great to see a range of exciting #bacteriology research at #bmh2024 Biomolecular Horizons 2024 Schembri Lab Kate Whyte McDevitt Laboratory ASM